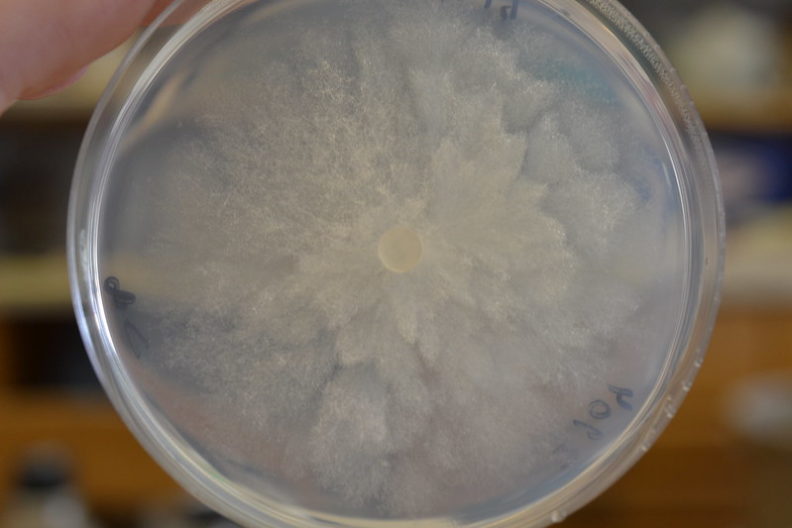
Phytophthora is grown in petri dishes filled with nutrient agar

Phytophthora ramorum Symptom ID Guide
Plant Pathogen
Phytophthora ramorum is a microscopic organism that has evolved to parasitize plants. It is a particularly harmful plant pathogen because it can kill many of the species it can infect (hosts).
Biosecurity
Phytophthora ramorum is a global concern because it can infect many different plant species and spreads relatively quickly. Unfortunately, it is challenge to manage due to its broad host range, long-term survival, and the variation in symptoms associated with infections. Furthermore, sometimes management practices (fungicides, biostimulants, etc.) can suppress the expression of visible symptoms, possibly resulting in the movement of an asymptomatic, but infected, plant.
More Information

Sudden Oak Death

General Information
Sudden Oak Death is a disease caused by Phytophthora ramorum. You can find more information about Sudden Oak Death at the links below:
Symptoms of Disease
Currently there are 5 tree species native to western North America that can be killed when they are infected with Phytophthora ramorum. These are tanoak (Lithocarpus densiflorus) and four oak species – Coast live oak (Quercus agrifolia), Canyon live oak (Q. chrysolepis), California black oak (Q. kelloggii), and Shreve oak (Q. parvula var. shrevei).
In Europe, P. ramorum has been found to cause stem cankers leading to death of European beech (Fagus sylvatica), European sycamore (Acer pseudoplatanus), Horse chestnut (Aesculus hippocastanum), Northern red oak (Q. rubra), Sessile oak (Q. petraea), Southern beech (Nothofagus obliqua), Southern red oak (Q. falcata), and Turkey oak (Q. cerris). None of these tree species are native to Washington State, although they can be found planted as ornamentals.
Similar Symptoms
There are many diseases and pests that produce symptoms similar to those of Sudden Oak Death. This guide will help you to rule out SOD by identifying some of the more commonly encountered pest problems. In addition, it will help determine whether the plant is potentially infected with P. ramorum and the need for a sample to be collected.
Some tree diseases that produce symptoms similar to P. ramorum are the following:
Phytophthora ramorum Symptoms
Phytophthora ramorum can produce leaf blotches, twig cankers, and shoot die-back on many plants. Generally, plants do not die as a result of P. ramorum infection. However, in some cases the dieback may be severe enough to kill the host plants. Huckleberry and madrone are the most common hosts in Washington State.
Other Online Symptom Guides
Plant Disease Diagnostics
Guidelines for submitting a sample
Visit our Sample Submissions Guidelines webpage for information to help determine whether it will be helpful to submit a plant sample for professional diagnostics.
WSU Plant and Insect Diagnostic Laboratory
The WSU Plant Clinic can provide diagnostic services to identify the cause of symptoms on Rhododendrons and other plant species.

Contact Us
Have more questions or concerns?
Contact us for more information or to schedule a site visit and Critical Control Point (CCP) Assessment. Fill out the webform on the right and we will reply when we are able.

WSU Puyallup Research & Extension Center, 2606 West Pioneer, Puyallup, WA, 98371-4998 USA
Home | Contact Us | Jobs | Citizen Science | Our Community | Support Our Program







